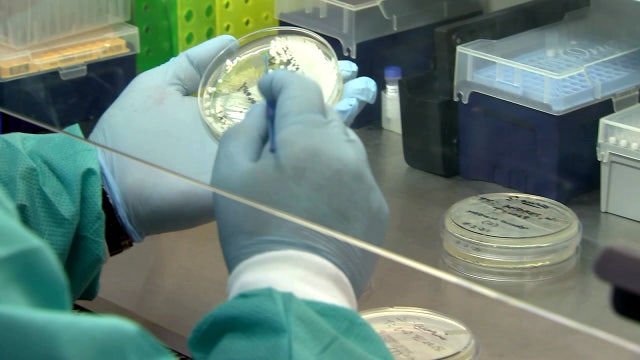
CDC: Florida breaks record with more than 21,000 new COVID cases

10-week-old puppy found in hot car 'screaming in pain' now recovering
According to Brevard County Sheriff Wayne Ivey, the original owners of the puppy, Brandon Mclaren and Mecaila Johnson, arrived back at the car 30 minutes after the puppy had been rescued.
According to Brevard County Sheriff Wayne Ivey, the original owners of the puppy, Brandon Mclaren and Mecaila Johnson, arrived back at the car 30 minutes after the puppy had been rescued.
Sheriff: Florida couple arrested for leaving puppy in hot car at mall
Deputies say the temperature inside the car had reached over 100-degrees and the puppy was crying in pain and 'near death.'
Deputies say the temperature inside the car had reached over 100-degrees and the puppy was crying in pain and 'near death.'
Florida woman wins $1 million on scratch-off ticket, finishes shift before cashing in
Wilma Todd originally thought she won $100,000,
Wilma Todd originally thought she won $100,000,
Volunteer High School: 'Hoax' shooter call prompted evacuation on first full day of class
A call about an active shooter inside a Tennessee high school prompted a major law enforcement response, but a sheriff's office believes it was a hoax after finding no suspect and no shooting injuries.
A call about an active shooter inside a Tennessee high school prompted a major law enforcement response, but a sheriff's office believes it was a hoax after finding no suspect and no shooting injuries.
Some ambulances forced to wait outside as Florida hospitals deal with rising number of patients
Pinellas County officials say some hospitals have so many COVID-19 cases that patients in ambulances may have to wait for up to an hour before the hospital can admit them. Although the most serious cases, like heart attacks and strokes, still take priority, the situation is putting a strain on fire departments and hospitals alike.
Pinellas County officials say some hospitals have so many COVID-19 cases that patients in ambulances may have to wait for up to an hour before the hospital can admit them. Although the most serious cases, like heart attacks and strokes, still take priority, the situation is putting a strain on fire departments and hospitals alike.
Surfside first responders among first to receive $1,000 bonuses in Florida
Back in March, discussions began to include $1,000 bonuses to Florida’s first responders in the state budget. This week, some of those checks were hand-delivered to them.
Back in March, discussions began to include $1,000 bonuses to Florida’s first responders in the state budget. This week, some of those checks were hand-delivered to them.
Florida mother dies from COVID-19 days after giving birth
A West Melbourne family is going through unimaginable heartbreak after a woman gave birth and then died shortly after due to COVID-19.
A West Melbourne family is going through unimaginable heartbreak after a woman gave birth and then died shortly after due to COVID-19.
Norwegian granted ability to allow 100% fully vaccinated cruises for passengers, crew
Norwegian Cruise Line's first sailing from Florida is scheduled on Aug. 15 on the Norwegian Gem departing from Miami.
Norwegian Cruise Line's first sailing from Florida is scheduled on Aug. 15 on the Norwegian Gem departing from Miami.
Legendary FSU football coach Bobby Bowden dies at 91
Bobby Bowden announced in July he had a terminal illness that his family later said was pancreatic cancer.
Bobby Bowden announced in July he had a terminal illness that his family later said was pancreatic cancer.
Fried seeks funds for schools after DeSantis threatens to withhold money over mask mandates
Gov. Ron DeSantis has threatened to withhold funding sources should a school district go against his executive order and impose a mask mandate. Now, one of his chief critics, Florida Agricultural Commissioner Nikki Fried, is firing back.
Gov. Ron DeSantis has threatened to withhold funding sources should a school district go against his executive order and impose a mask mandate. Now, one of his chief critics, Florida Agricultural Commissioner Nikki Fried, is firing back.
Over 15-foot python nabbed during 2021 Florida Python Challenge
The results are in for the 2021 Florida Python Challenge with 223 invasive pythons caught. The 10-day-event last month more than doubled the number of pythons captured the previous year.
The results are in for the 2021 Florida Python Challenge with 223 invasive pythons caught. The 10-day-event last month more than doubled the number of pythons captured the previous year.
COVID-19 spike: In Florida hospitals, 'there are only so many beds'
On Tuesday, the Centers for Disease Control and Prevention reported more than 50,000 new COVID-19 cases in Florida during a three-day span, raising the seven-day average to one of the highest counts since the pandemic began.
On Tuesday, the Centers for Disease Control and Prevention reported more than 50,000 new COVID-19 cases in Florida during a three-day span, raising the seven-day average to one of the highest counts since the pandemic began.
Passenger taped to seat after allegedly groping flight attendants
A man on a Frontier Airlines flight ended up being taped to his seat after a series of incidents including allegedly groping female flight attendants and punching a male flight attendant in the face.
A man on a Frontier Airlines flight ended up being taped to his seat after a series of incidents including allegedly groping female flight attendants and punching a male flight attendant in the face.
Polk sheriff: Disney employees, nurse and California man among 17 arrested in undercover child predator sting
Seventeen suspects thought they were speaking to young teens online, but it turned out they were speaking to undercover detectives across several agencies in central Florida. Among those arrested include Disney employees, a registered nurse, and a married man visiting from California, officials say.
Seventeen suspects thought they were speaking to young teens online, but it turned out they were speaking to undercover detectives across several agencies in central Florida. Among those arrested include Disney employees, a registered nurse, and a married man visiting from California, officials say.
Man running on water inside 'bubble' for charity washes up on Florida beach
The Flagler County Sheriff's Office said a strange vessel washed ashore on Saturday morning. It turned out to be a Central Florida man who was ‘walking on water’ for charity.
The Flagler County Sheriff's Office said a strange vessel washed ashore on Saturday morning. It turned out to be a Central Florida man who was ‘walking on water’ for charity.
Mother found shot to death in car alongside her 2 unharmed, ‘terrified’ children, police say
St. Pete police are investigating after a mother was found dead in a car from an apparent gunshot wound alongside her two unharmed, but terrified children.
St. Pete police are investigating after a mother was found dead in a car from an apparent gunshot wound alongside her two unharmed, but terrified children.
Florida COVID hospitalizations break record
A day after it recorded the most new daily cases since the start of the pandemic, Florida on Sunday broke a previous record for current hospitalizations, as the number of patients in hospitals because of COVID-19 once again broke through the 10,000-person threshold.
A day after it recorded the most new daily cases since the start of the pandemic, Florida on Sunday broke a previous record for current hospitalizations, as the number of patients in hospitals because of COVID-19 once again broke through the 10,000-person threshold.
CDC: Florida breaks record with more than 21,000 new COVID cases
Federal health officials say Florida has reported 21,683 new cases of COVID-19, the state's highest one-day total since the start of the pandemic.
Federal health officials say Florida has reported 21,683 new cases of COVID-19, the state's highest one-day total since the start of the pandemic.
Massive alligator shows up at front door of Florida home, tries to meet neighbor's dog
Resident Mike Ninowski says the gator was about 10 to 11-feet long and weighed around 400 pounds!
Resident Mike Ninowski says the gator was about 10 to 11-feet long and weighed around 400 pounds!
PHOTOS: Kids swim in flooded streets at Disney's Magic Kingdom
"That’s really cool. Disney be like 'that’s an extra 50.00 for water park entrance.'"
"That’s really cool. Disney be like 'that’s an extra 50.00 for water park entrance.'"